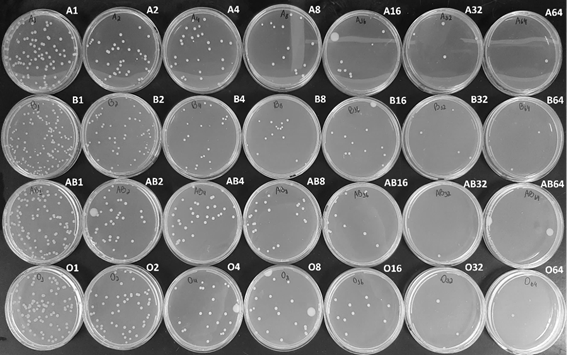

INTRODUCTION
The ABO blood system consists mainly of two antigens (A and B) formed by carbohydrates, with four possible phenotypes A, B, AB, and O, and the most frequent among the population of Latin America are O, A, B, and AB, respectively, according to Alvarado et al. (2020); Bermúdez et al. (2012) and Pereira & Siebert (2020). The antigens of the ABO system are: A, B, and H, and the antigens A and B are autosomal codominant, and the H antigen (phenotype O) is autosomal recessive. The FUT1 gene, coded on chromosome 19, is responsible for regulating the production of the H antigen, and the ABO gene, coded on chromosome 9, is responsible for regulating the production of antigens A and B; these antigens are present in the blood (erythrocytes), among other tissues such as bone marrow, placenta, and spleen. If expressed, secretive status, coded by the FUT2 gene, antigens of the ABO blood system can be found in tissues such as the trachea, parotid and salivary glands, gastric and intestinal mucosa, uroepithelial cells (bladder and kidney) and female reproductive tract (vagina, cervix, and ovary) (Cooling, 2015; Pereira & Siebert, 2020; Silva-filho et al., 2020).
Antibodies against ABO antigens (anti-A and anti-B) can be developed by alloimmune and natural stimulation. Alloimmune stimulus occurs when there is contact with incompatible ABO red cells antigens and may occur through transplantation, transfusion, and/or pregnancy. Natural anti-ABO formation happens through contact with bacteria of the microbiota that have similar antigens to those of the ABO blood group, passively and constantly stimulating the formation of antibodies (Geraldo, 2013).
The interaction between ABO antigens and microorganisms has been researched, including those in the microbiota, especially the action of antigens and ABO antibodies in susceptibility to infectious diseases (Chakrani et al., 2018; Ewald & Sumner 2016; Stowell et al., 2010; Uchida et al., 2006). The association of the ABO system with various diseases and their degrees of severity has been linked to the expression of antigens in the red cell membrane and histocompatibility, which serve as pathogens receptors. However, the relationship may also be associated with the presence or not of natural antibodies in this blood group, according to Cooling (2015); Ewald & Sumner (2016); Garratty (2000); Geraldo & Martinello (2020). In particular, antigens of the ABO system may interact with bacteria to aid the adherence to tissues and/or cells or inhibit them (Cooling, 2015; Uchida et al., 2006).
Using anti-ABO antibodies may be a strategy for combating pathogens (Kappler & Hennet, 2020; Xia et al., 2020). Researches indicate that the presence of anti-A in human plasma provides lower rates of development of SARS-CoV2, according to Gérard et al. (2020), and Xia et al. (2020), and the absence of anti-A represents a facilitator for COVID-19 infection, according to Breiman et al. (2020) and Hoiland et al., (2020). For other viruses, such as the Human Immunodeficiency Virus (HIV) (Chanzu et al., 2015) and Norovirus (Hosoi, 2008; Hutson et al., 2003) this angle of research has already been carried out. Researchers have explored using natural anti-A, anti-B, and anti-Galα1-3Gal antibodies to neutralize other virus species through bonding as a protection strategy for individuals (Onsten, 2010).
In addition, some researchers also evaluated the action of anti-ABO antibodies on bacteria such as Vibrio cholerae and Helicobacter pylori, according to Cooling, 2015; Galili et al., 1988 and Guerra et al., 2013, do not make it clear whether the action of these antibodies is bactericidal or bacteriostatic (Geraldo et al., 2016; Hedestam et al., 2008; Onsten, 2010; Stowell et al., 2010; Uchida et al., 2006; Zhang et al., 2013).
This research aimed to determine the minimum titer of the Escherichia coli bacteria capable of undergoing in vitro bactericidal action of a given titer of human anti-ABO antibodies.
MATERIALS AND METHODS
Selection of the blood samples
Human blood samples were obtained from volunteers, and for their inclusion in the tests, they should meet the following criteria: age between 18 and 69 years old; individuals of either sex. In order to evaluate the exclusion criteria, a questionnaire was applied to the research subjects, since individuals who have used antibiotics and/or anti-inflammatory drugs in the last 90 days and/or individuals who have undergone surgical and/or dental procedures in the previous 90 days were excluded from recruitment to obtain biological samples. After treating two biological blood samples, one with EDTA anticoagulant and another without anticoagulant (5 mL each), the titer of anti-ABO antibodies was evaluated. Individuals with antibody titers lower than 1:32 were excluded from the research. The research was carried out with a volunteer from each blood group A, B, AB, and O.
This research was approved by the Ethics and Research Committee of Universidade do Vale do Itajaí (UNIVALI) upon advice number 4.013.440.
Phenotyping of the ABO system
The determination of the phenotyping of the ABO system of the individuals was performed by centrifugation of the sample with EDTA anticoagulant for 5 minutes at 1,000 g. A 3% red blood cell suspension was prepared in sterile saline (0.9% sodium chloride solution).
The determination of the ABO phenotype was performed through direct and reverse testing by the tube technique, according to the Ministério da Saúde (2014). Monoclonal anti-A, anti-B, and anti-AB reagents and A1 and B red blood cells reagents from Bio-Rad Laboratories® were used. The reactions were read after additional centrifugation of the tubes for 15 seconds at 2,326 g. The tube technique followed the pattern of reading the reaction intensity, according to Girello and Kuhn (2016).
Determination of anti-ABO antibodies titers
The determination of the titer of anti-A and anti-B antibodies was performed according to Judd et al. (2008) through serial plasma titration of the individuals. A dilution battery was performed for anti-ABO antibodies up to 1:512 in 0.9% sterile saline at room temperature. Samples collected with EDTA anticoagulant were centrifuged for 5 minutes at 1,000 g, and 50 µL plasma was added to the tubes accompanied by 50 µL A1 3% red blood cell suspension of the Bio-Rad Laboratories® reagent was added to the previously identified tubes of blood group B, and 50 µL B 3% red blood cell suspension of the Bio-Rad Laboratories® reagent was added to the previously identified tubes of blood group A; for blood group O both titrations were performed to evaluate anti-A and anti-B antibodies. Subsequently, the tubes were homogenized and centrifuged at 2,326 g for 15 seconds. The reaction was read by verifying the presence or absence of hemolysis and/or agglutination according to Girello and Kuhn (2016). The antibody Titus was determined when agglutination occurred in the last dilution tube in which the intensity of agglutination observed was 1+. Elevated ABO antibody titers were considered those with positive reaction in dilution equal to or greater than 1:32, adapted according to the criteria adopted by the English National Health Service Blood and Transplant (NHSBT) (Win, 2011).
Preparation of bacterial inoculum
To determine the bacteria titer, a solution with Escherichia coli (ATCC 25922) was prepared by the suspension of 5 colonies isolated in 5 mL sterile saline from the bacterium previously grown in Mueller-Hinton agar for 24 hours. The concentration of cells was adjusted by comparing the suspension and number 0.5 (equivalent to 1.5. 108 cells/mL) from MacFarland Scale, followed by dilution to reach a concentration of 1.5.10³ cells/mL.
Bactericidal Test
Solutions for the bactericidal tests were prepared through serial dilutions (1:1 to 1:64 parts) in sterile microcentrifuge tubes. 100 µL inoculum was added to the microcentrifuge tubes in dilutions 1:1 and 1:2, and then serial inoculum dilutions were started in the microcentrifuge tubes at 1:2, 1:4, 1:8, 1:32 and 1:64 dilutions, adding 100 µL 0.9% sterile saline.
After the preparation of serial dilutions, 100 µL of serum from volunteers was added to the microcentrifuge tubes. Serum preparation was performed by separating red blood cells using centrifugation of 1,000 g for 10 minutes and separated by blood groups A, B, O, and AB (negative control) in each dilution series. The preparation of the final solution (saline with inoculum + serum) did not exceed 20 minutes, aiming at preserving the concentration of bacterial cells. Subsequently, 100 µL each solution was inoculated (saline with inoculum + serum) by spreading with the Drigalski inoculation loop in Petri plates with Mueller-Hinton agar (identified according to blood groups and dilutions) incubated at 35 °C for 24 hours. After incubation, the colony-forming units (CFU) were counted.
Positive Control of Bactericidal Test
To evaluate the capacity of bacterial growth, inoculations were performed in Mueller-Hinton agar with 100 µL of the inoculum and dilutions from 1:2 to 1:64 in 0.9% sterile saline solution; by spreading with the Drigalski inoculation loop. The plates were incubated at 35 °C for 24 hours, with a posterior count of the colony-forming units (CFU).
Negative Control of Bactericidal Test
Sample without antibodies from the ABO system
To evaluate the bactericidal potential of the antibodies of the ABO system, inoculations identical to those of the Bactericidal Test with the serum of blood group AB in Mueller-Hinton agar were performed; by spreading with the Drigalski inoculation loop. It was used as a negative control due to the absence of characteristic antibodies of the phenotype.
Controls were performed to certify the sterility of the culture medium, saline, and human serum samples used in the research.
Statistical analysis
The Tukey Multiple Comparison Test was applied to the experimental data, with a 95% confidence interval to verify the correlation between the concentration of bacteria and antibody titer against ABO antigens, using the GraphPad Prism® program version 8.0 of 2019. ANOVA Two-way analysis was performed to evaluate the interaction force between the results of dilutions with a 95% confidence interval. The research was carried out in duplicate (tests 1 and 2) with an interval of 21 days for the new biological sample collection of the same volunteers. The comparison of the blood group titers and the CFU of assays 1 and 2 was confirmed by paired T-Test analysis (p<0.05) with a 95% confidence interval.
RESULTS
Ten volunteers (100%) between the ages of 18 and 69 were initially recruited, and no volunteer was excluded from the survey when applying the questionnaire. After applying the exclusion criteria, six of the recruited volunteers (n=6 or 60%) were found to have anti-ABO antibody titers less than 1:32 and were subsequently excluded from the research. Regarding the selection of volunteers, one individual from each blood group of the ABO system (blood group A, B, AB, and O) was chosen based on the similarity of their antibody titers. This variable was considered important in the Bactericidal Test. Therefore, a total of four participants were selected (n=4 or 40%).
In test 1, antibody titration selected for participation in the Bactericidal Test was: 1:128 for blood group A, 1:64 for blood group B, 1:32 (anti-A), and 1:64 (anti-B) for blood group O. In test 2, the antibody titration used in the Bactericidal Test was: 1:128 for blood group A, 1:32 for blood group B, 1:128 (anti-A) and 1:256 (anti-B) for blood group O.
There was no significant difference in the Bactericidal Test between tests 1 and 2 in blood groups A (p=0.1573), B (p=0.1137), AB (p=0.0762), O (p=0.0994), and Positive Control (p=0.1473), as shown in Figure 1.

Figure 1 Comparison of Colony Forming Units (CFU) counts and paired T-Test of Test 1 and 2 of blood groups A, B, AB, O, and positive control.
There was a significant difference in pure human serum when blood group A x Positive Control (p<0.0001) was analyzed; likewise for blood group B x Positive Control (p<0.0001); blood group AB x Positive Control (p<0.0001) and blood group O x Positive Control (p<0.0001), corroborating with the results found in the study by Gomes et al. Although Figure 2 and Table 1 shows a reduction in the CFU count, no significant difference was observed in the other dilutions. Table 1 was generated through the mean colony count carried out in the test 1 and 2. The colony forming units could be seen in Supplementary Material Fig S.1 and S.2.

Legend: *= data that showed significant difference; CFU = Colony Forming Units.
Figure 2 Colony Forming Units in relation to bacterial dilutions with anti-ABO antibodies, mean and standard deviation.
Table 1 Colony Forming Units of blood groups A, B, AB, and O and positive control, mean ± standard deviation.
| Sample | Blood Group A | Blood Group B | Blood Group AB | Blood Group O | Positive Control | |||||
|---|---|---|---|---|---|---|---|---|---|---|
| mean | sd* | mean | sd | mean | sd | mean | sd | mean | sd | |
| Pure | 72.00 | 46.67 | 96.00 | 76.37 | 84.00 | 33.94 | 77.50 | 65.76 | 281.50 | 43.13 |
| 1:2 | 40.00 | 9.90 | 41.50 | 24.75 | 34.00 | 29.70 | 34.50 | 17.68 | 98.00 | 8.49 |
| 1:4 | 22.50 | 10.61 | 13.50 | 10.61 | 20.50 | 3.54 | 25.00 | 12.73 | 73.50 | 14.85 |
| 1:8 | 11.50 | 3.54 | 10.00 | 7.07 | 13.50 | 13.44 | 16.50 | 16.26 | 45.50 | 23.33 |
| 1:16 | 9.00 | 0.00 | 6.00 | 5.66 | 7.50 | 4.95 | 8.00 | 4.24 | 23.50 | 6.36 |
| 1:32 | 3.00 | 1.41 | 2.50 | 3.54 | 3.00 | 0.00 | 1.00 | 0.00 | 8.50 | 0.71 |
| 1:64 | 1.50 | 0.71 | 2.50 | 2.12 | 3.00 | 2.83 | 0.50 | 0.71 | 3.50 | 0.71 |
* Standard deviation.
In the statistical comparisons between blood group A x other ABO groups, Blood group B x other ABO groups, blood group AB x other ABO groups, and blood group O x other ABO groups, no significant difference was found (p<0.05), moreover no significant difference ABO intergroups in the serum, even if there was interaction force between the results (p=0.004) and Row Factor of p<0.0001.
In addition, the negative controls performed did not show CFU growth.
DISCUSSION
Bactericidal Test analysis
The mean Colony Forming Units (CFU) with serum was 72, 96, 84 e 77.5 CFU/mL for blood groups A, B, AB, and O, respectively, and a significant difference between the amount of CFU and the antibody titration of volunteers was observed. However, in the other dilutions, no significant bactericidal effect was shown in any blood group. The main variables capable of interfering with the Bactericidal Test are the concentration of the inoculum and the titration of anti-ABO antibodies, and there are numerous hypotheses addressed in this research of how these variables can present themselves and how they could justify the bactericidal action in serum, but not in bacterial dilutions. A hypothesis is that the bactericidal activity could be related to the isometry of the antigen-antibody binding. Antibodies are mostly formed by amino acids, thus having an amine or carboxyl termination in the antigen-binding region (bacteria), the light chain region of immunoglobulins. According to the terminal atomic structure this isomeric characteristic can be divided into levogyrous and dextrogyrous. In the case of antibodies, depending on structural fluctuations, the isometry may influence the affinity between bacterial antigens and anti-ABO antibodies, which can make it weaker and interfere with the opsonization of bacteria, according to Jain et al. (2017) and Jacobs et al. (2015). Although neither the study of the atomic isometry of bacterial antigens nor the light chain of human immunoglobulins has been carried out, this research hypothesizes that when bacterial dilution was performed, there was a decline in antigen-antibody affinity. Consequently, there is a decline in the force of opsonization of the antibodies and, finally, the bactericidal effect.
Another hypothesis for significant effect with serum, but not with dilutions of bacterial solutions, is the steric impediment, which relates the concentration and characteristic of antibodies to bacterial antigens. One of the molecular characteristics of antibodies is the electrical charge of antigen binding terminals, which are amino (positive) and carboxyl (negative). By performing the opsonization function, the antibodies need to reach the antigen. Consequently, there is an approximation between the antibodies themselves, and depending on the structural conformation, possibly resulting in electrical repulsion. Thus, the repulsion between the antibodies can occur, hindering contact whit the antigen (bacteria) and preventing opsonization. Therefore, the steric impediment would become a viable justification for the bactericidal effect found in the research (Focosi, 2020; Jacobs et al., 2015; Velloso, 2018). Figure 3 represents the hypothesis of electrical repulsion of bacterial antigens with anti-ABO antibodies.
The paired T-Test of the blood groups A, B, AB, and O (Figure 1) was performed to analyze whether there was a statistically relevant difference between tests 1 and 2 because of the time interval between the tests and antibody titration. Thus, it was evidenced that the performance of test 2 would not have been necessary to achieve the research objective. Only, one test would have been sufficient. As found in the research of Hirata & Haikal (2021), there was no statistical difference between the first and second analysis.
Selection of volunteers, phenotyping, and ABO titration
In the present study, blood samples from 4 volunteers were used, being sufficient to achieve the research objective.
A hypothesis for changes in the findings of this research was the titration of anti-ABO antibodies. Due, to the concentration of antibodies between the volunteers of each blood group being different, there is a possibility of interference, but the titration difference only becomes relevant when there is a change in 2 titers or more (Maranho, 2016; Rosa, 2018).
Although contamination was evidenced in some blood group plates of the Bactericidal Test of tests 1 and 2, colony count was not affected due to the specificity of the macromorphological characteristics of the E.coli. And also, the negative control plates have not been contaminated.
CONCLUSION
The results of this study indicated that the anti-ABO antibodies have a bactericidal action against Escherichia coli bacteria, reducing the growth of CFU/mL in the pure inoculum. The statistical results of multiple comparison between the antibody titer and bacterial dilutions did not show a significant effect (p>0.05) capable of demonstrating the bactericidal action in the serum of the volunteers. The paired T-Test indicated that there was no statistical difference (p>0.05) when comparing the bactericide tests of Test 1 and 2, indicating that Test 2 had no significant influence on the results. Although there are theories that justify the results found, further studies are suggested to explore other possible variables that may influence the results of the analysis, as well as the number of volunteers and bacterial species for example.